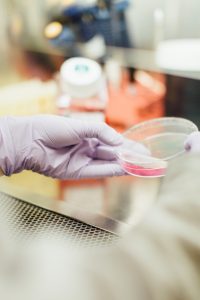
Dentists undertake pioneering research

Latest News
A group of dentists undertake pioneering research that could expand the possibilities of modern medicine. The researchers from The UNLV are developing a method that allows them to extract tooth pulp in such a way that it garners four times the amount of stem cells than previous methods. These stem cells can then be replicated, and in turn, can be used to treat an array of medical issues.
A group of dentists undertake pioneering research that could expand the possibilities of modern medicine. The researchers from The UNLV are developing a method that allows them to extract tooth pulp in such a way that it garners four times the amount of stem cells than previous methods. These stem cells can then be replicated, and in turn, can be used to treat an array of medical issues.
Dr. James Mah, director of the university’s advanced orthodontics program spoke out about this potentially life-saving research. “Stem cells can be extracted from nearly any living tissue. In fact, stem cells can even be found in tissues of the deceased. The biggest challenges with stem cells are gathering enough of them to work with and keeping them viable until they are needed.”
This new research could help facilitate groundbreaking treatment by using stem cells to reproduce healthy cells in the body of the sufferer. Because of this, people with chronic or terminal illnesses could see their symptoms reduced, or vanish altogether. The research continues.
Pearl Dental Clinic is open 7 days a week from 9am to 10pm. You can book an appointment by calling us on 02085479997 or emailing us or booking an appointment online.

